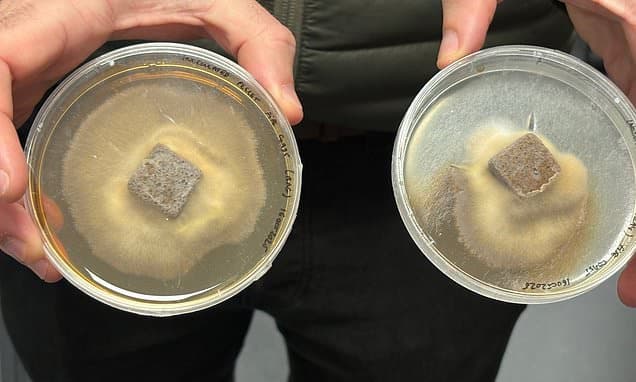
Fungi Power: Mushrooms Regrowing Forests Faster

Home / Environment / Fungi Power: Mushrooms Regrowing Forests Faster
Fungi Power: Mushrooms Regrowing Forests Faster
2 Jan
Summary
- Mushroom pellets enhance tree roots, improving survival by up to 50%.
- Company curates Earth's largest library of fungal specimens globally.
- A £4.5 million investment will expand work into North America.
A Scottish company, Rhizocore Technologies, is employing the unique capabilities of fungi to significantly advance forest regrowth initiatives. Their innovative "rhizopellets" are engineered to revitalize soil, improving tree survival rates by as much as half. This advancement is crucial as deforestation and human activities often deplete the essential mycorrhizal fungi trees need to flourish.
Rhizocore is dedicated to collecting and cataloging a vast array of fungal species worldwide, aspiring to create the planet's most extensive fungal library. Each pellet is carefully impregnated with specific fungal cultures, tailored to enhance tree root systems and ensure optimal growth in diverse environments. A recent collaboration with Forestry and Land Scotland demonstrated a 25% improvement in tree survival rates.
With a recent £4.5 million investment, Rhizocore Technologies is set to broaden its operations into North America. The company's founder emphasized harnessing fungal "superpowers" for ecological restoration. Their work spans reforestation and commercial forestry projects across the UK and Europe, fostering beneficial relationships between trees and fungi for global environmental betterment.




